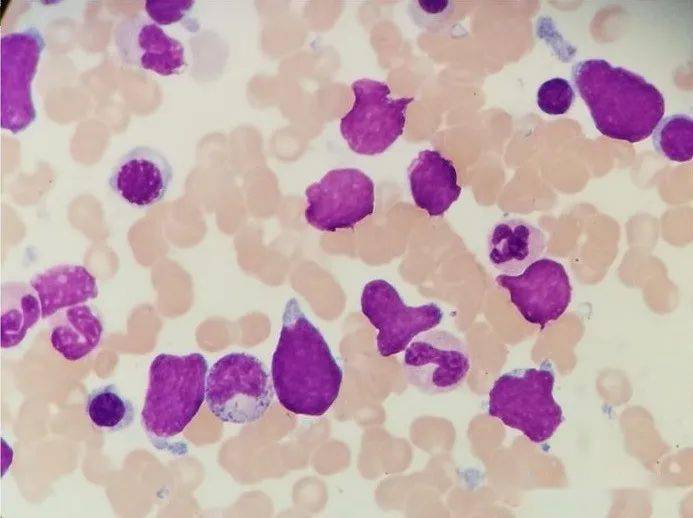
骨髓涂片b超检查淋巴细胞甲功 肿瘤标志物免疫球蛋白 补体凝血检查

正常淋巴结b超图

超声问答61这个颈部淋巴结应该如何考虑?_甲状腺炎_研究_病例
图片尺寸776x576
遇到这样的颈部肿大淋巴结你怎么考虑
图片尺寸1080x379
遇到这样的颈部肿大淋巴结你怎么考虑
图片尺寸1080x379
遇到这样的颈部肿大淋巴结你怎么考虑
图片尺寸660x563
超声问答61这个颈部淋巴结应该如何考虑?_甲状腺炎_研究_病例
图片尺寸776x576
超声问答61这个颈部淋巴结应该如何考虑?_甲状腺炎_研究_病例
图片尺寸776x576
超声问答61这个颈部淋巴结应该如何考虑?_甲状腺炎_研究_病例
图片尺寸776x576
67发热,颈部淋巴结大,只想到 eb 病毒感染就错了!_诊断_检查_组织
图片尺寸503x566
超声问答61这个颈部淋巴结应该如何考虑?_甲状腺炎_研究_病例
图片尺寸776x576
超声问答61这个颈部淋巴结应该如何考虑?_甲状腺炎_研究_病例
图片尺寸776x576
b超检查淋巴细胞甲功 肿瘤标志物免疫球蛋白 补体凝血检查贫血检查
图片尺寸1080x1152
b超检查淋巴细胞甲功 肿瘤标志物免疫球蛋白 补体凝血检查贫血检查
图片尺寸1080x1026
图 16 恶性淋巴瘤图片来源:作者提供图 17 恶性淋巴瘤病理诊断图片
图片尺寸768x576
技术好!b超单有这个一般是女孩"口口声声"-第1张图片-空竹博客
图片尺寸640x463
妇幼健康丨儿童腹痛常见病之肠系膜淋巴结肿大_检查
图片尺寸298x260
16岁少女咳嗽不止,经检查发现居然是结核_诊断_患者_淋巴结
图片尺寸858x469
临近新年之际,年仅35岁妻子竟身患淋巴瘤,请求给我妻子一个活下去的
图片尺寸1279x1705
骨髓涂片b超检查淋巴细胞甲功 肿瘤标志物免疫球蛋白 补体凝血检查
图片尺寸693x518
弥漫大b细胞淋巴瘤
图片尺寸1080x900
南海九院内三科联合b超科成功开展超声引导下颈部淋巴结穿刺活检术
图片尺寸1080x1625
猜你喜欢:淋巴结正常淋巴结图片淋巴结肿大图片b超图片正常图片子宫淋巴结图片真人颈部淋巴结位置图片正常子宫b超图耳后淋巴结位置图片b超图片正常图片眼部b超正常和异常图b超图片正常图片真实正常阑尾b超图宝宝脖子上淋巴结图片淋巴结在哪淋巴结人流后正常b超图没怀孕的正常b超图正常b超检查结果图片颈部淋巴结淋巴结在哪里部位图片淋巴结是什么样子图片淋巴结全身颈部淋巴结肿大淋巴结肿大正常环位置b超图片颈部淋巴结分区淋巴结是什么东西腋下淋巴结正常b超报告单图片腹股沟淋巴结肿大HDPE虹吸管麻将图解上升K线韩雪宋轶合作电视剧f1斯帕赛道耐克nike运动鞋女教画一个人哈利波特单人图片数字连点成画节日海报 中秋节数字8像麻花图片书的小图标